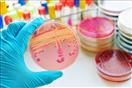
تعفن الدم

طفلة بريطانية فارقت الحياة بعد 12 ساعة من ظهور هذه الأعراض.. فما القصة؟
كتبت- آلاء نبيل
-
عرض 11 صورة

-
عرض 11 صورة

-
عرض 11 صورة

-
عرض 11 صورة

-
عرض 11 صورة

-
عرض 11 صورة

-
عرض 11 صورة
-
عرض 11 صورة

-
عرض 11 صورة

-
عرض 11 صورة

-
عرض 11 صورة

ساعات صعبة عاشها أبوان لطفلة لم يتجاوز عمرها الـ6 سنوات، إذ شعرت بأعراض مفاجئة، تمثلت في ألم شديد بالبطن والقلب، ولكن لم يكن في الحسبان أنها علامات على وفاة طفلتهما.
نُقلت الطفلة "ميلي روز ستيراب"، إلى المستشفى بمدينة مانشستر في إنجلترا، بعد شكواها من الأعراض، وجرى التعامل معها، ونصح الأطباء الوالدين ببعض التعليمات للقيام بها حال تعافيها وعودتها إلى المنزل، وفقًا لما ذكرته صحيفة "thesun" البريطانية.
ولكن حدث ما لم يكن متوقعا، فبعد مرور 12 ساعة من شعورها بالأعراض فارقت الطفلة الحياة بشكل مفاجئ، وتركت والديها في صدمة شديدة دون معرفة سبب وفاتها، بعدما وصلت دقات قلبها إلى 135، وانخفاض درجة حرارة الجسم، والشعور بالإرهاق والتعرق بطريقة مفرطة.
الأعراض جعلت الأطباء يعتقدون أن سبب الوفاة، الإنتان وهي حالة تعفن الدم، تنتج عن عدوى تؤثر على كفاءة عمل أعضاء الجسم، ويصاب الشخص بانخفاض في ضغط الدم، وتلف الرئتين والكبد والكلى وأخيرًا القلب، مما يؤدي إلى الوفاة في الحال.
وقال والد الطفلة، إن آخر شيء كان يتوقعه توقف قلب ابنته بشكل مفاجئ، ما جعلهم في حالة ذهول وعدم استيعاب.
اقرأ ايصًا
مشروب شائع يسبب رائحة الفم الكريهة- طبيب يحذر
7 علامات غير متوقعة تكشف إصابتك بسرطان البروستاتا
8 فئات أكثر عرضة لخطر ارتفاع نسبة الكوليسترول في الدم
حسام موافي يكشف: عدم تناول هذا المشروب في الصيف يهدد صحتك
خبير تغذية ينصح بتجنب شرب الشاي ليلا لهذا السبب


























